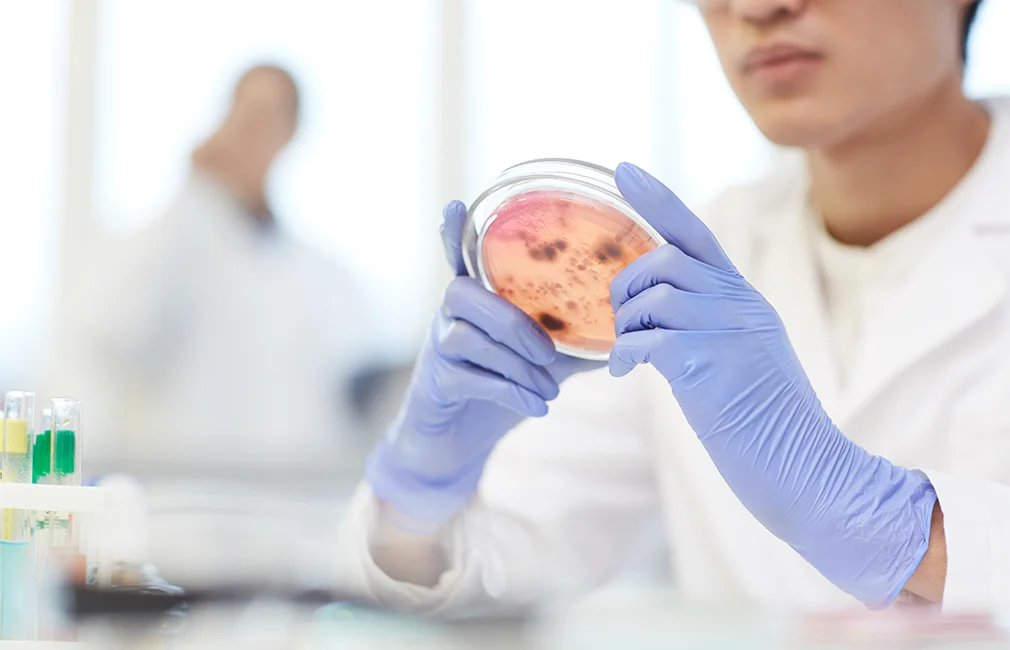

Stress und Hautalterung: Welche Pflege die Jugend der Haut bewahrt
Unsere Haut ist ein Spiegel unseres Lebensrhythmus. Sie ist äusseren Einflüssen wie Umweltverschmutzung und Sonne ausgesetzt, dazu kommen Stress und zu wenig Schlaf. Mit der Zeit verliert sie an Geschmeidigkeit und Ausstrahlung. Hautalterung ist ein natürlicher Prozess, der früh beginnen kann, teils schon in den Zwanzigern, und durch verschiedene Faktoren beschleunigt wird. Falten, nachlassende Spannkraft und geringere Festigkeit sind zwar unvermeidbar. Mit den richtigen Pflegeroutinen und gezielten Wirkstoffen lässt sich der Prozess jedoch verlangsamen, sodass Festigkeit, Ausstrahlung und Vitalität länger erhalten bleiben.
Hautalterung und Stress: die Mechanismen verstehen
Die Hautalterung wird von zwei grundlegenden Mechanismen geprägt.
Erstens dem intrinsischen Alterungsprozess, beeinflusst von Alter, Genetik und hormonellen Veränderungen. Bereits ab den Zwanzigern sinkt die Produktion von Kollagen und Elastin schrittweise. Das mindert die Festigkeit und begünstigt erste feine Linien. Auch die Zellerneuerung verlangsamt sich, wodurch der Teint weniger gleichmässig wirkt.
Zweitens wirken äussere Faktoren beschleunigend. Chronischer Stress steigert die Cortisolproduktion und stört das Gleichgewicht der Haut. Er fördert Entzündungen, schwächt die Hautbarriere und begünstigt Feuchtigkeitsverlust. Umweltverschmutzung und UV-Strahlung erzeugen freie Radikale, die oxidativen Stress auslösen und die stützenden Fasern der Haut angreifen. Das Ergebnis sind stärker sichtbare Falten, erschlaffte Konturen und ein matteres Hautbild.
Sobald diese Mechanismen einsetzen, zeigen sich mehrere strukturelle und ästhetische Veränderungen:
- Verlust von Kollagen und Elastin: Die Festigkeit nimmt ab, das Gewebe erschlafft, Falten treten deutlicher hervor.
- Geschwächte Hautbarriere: Sie schützt weniger, Wasser entweicht leichter, die Haut trocknet schneller aus.
- Oxidativer Stress: Durch freie Radikale werden Stützfasern geschädigt, der Teint wirkt fahl und die Alterung schreitet voran.
- Verlangsamte Zellerneuerung: Die Regeneration dauert länger, die Haut erscheint weniger glatt und weniger strahlend.
Diese Veränderungen sind zunächst subtil. Mit der Zeit werden sie deutlicher und machen den Einfluss von Alterung und Umweltfaktoren sichtbar.
Anzeichen der Hautalterung vorbeugen: tägliche Gewohnheiten und die Rolle natürlicher Wirkstoffe
Einen schützenden Lebensstil pflegen
Sonneneinstrahlung begrenzen, regelmässigen Schlaf fördern und sich antioxidantienreich ernähren. Diese einfachen Gewohnheiten reduzieren die Folgen von Stress und unterstützen die Hautgesundheit langfristig.
Ausgewählte Wirkstoffe zur Revitalisierung und zum Schutz der Haut
Einige Inhaltsstoffe überzeugen durch ihre Wirksamkeit und unterstützen die Haut gezielt:
- Hyaluronsäure & Q10: Spenden tiefenwirksame Feuchtigkeit, polstern die Haut auf und unterstützen die Regeneration.
- Vitamin E: Ein starkes Antioxidans, das vor oxidativem Stress schützt und die Ausstrahlung des Teints bewahrt.
- Aloe Vera, Cupuaçu-Butter & pflanzliche Öle: Nähren, beruhigen und verbessern die Geschmeidigkeit der Haut.
- Pflanzenextrakte (Hagebutte, Hamamelis, Salbei, Kamille): Revitalisieren und tragen zu einem strahlenden Teint bei.
Im Zusammenspiel stärken diese Wirkstoffe die Haut und verzögern sichtbare Zeichen der Zeit.
Die Synergie des Biences Anti-Falten Sets
Das Biences Anti-Falten Set vereint zahlreiche Wirkstoffe in einer kompletten Routine für Haut, die unter Stress steht oder erste Alterszeichen zeigt. Jedes Pflegeprodukt liefert eigene natürliche Wirkstoffe und adressiert präzise Hautbedürfnisse.
- Augenkonturgel gegen Falten & Augenringe
Reich an Aloe Vera, Hagebutte, Hamamelis und Salbei. Es versorgt die empfindliche Augenpartie mit Feuchtigkeit, mildert Augenringe und glättet feine Linien für einen sichtbar erholten Blick.
- Glättendes & Anti-Falten hydroaktives Serum
Mit Mandelöl und Aprikosenöl, Aloe Vera, Cupuaçu-Butter, Vitamin C und E sowie D-Panthenol. Es polstert die Haut auf, festigt sie und optimiert die Wirkung der anschliessend aufgetragenen Pflegeprodukte.
- Anti-Falten Creme mit Q10 & Hyaluronsäure
Formuliert mit Q10, Hyaluronsäure, Vitamin A und E, Bienenwachs, Aloe Vera, Cupuaçu-Butter sowie nährenden Aprikosen- und Mandelölen. Sie spendet intensive Feuchtigkeit, verbessert die Geschmeidigkeit und hilft, vorzeitiger Hautalterung vorzubeugen.
Bei täglicher Anwendung begleitet das Biences Anti-Falten Set die Haut in ihrer natürlichen Entwicklung und unterstützt sie dabei, geschmeidig, fest und sichtbar strahlender zu bleiben.
3 essentiels anti-âge

